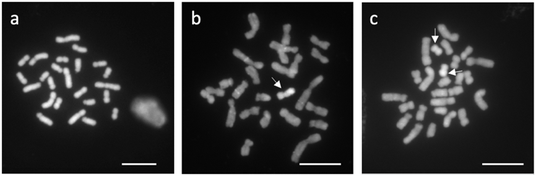

プレスリリース配信元:国立大学法人千葉大学
■ポイント:
○ 漢方原料「蒼朮」の原料となる植物ホソバオケラで、機能が未知であるB染色体を発見しました。
○ このB染色体は、メスとオスの両方から優先的に後代に伝達される生き残り戦略を持っていました。
○ このB染色体が持つ生育や薬用成分の種類・含量に及ぼす影響はまだ明らかになっていません。
○ このB染色体のDNAの単離に成功しました。今後、B染色体の有無をPCR検査で簡便に決定でき、この技術はホソバオケラの品種改良に活用されることが期待されます。

図1 ホソバオケラの花
■研究の概要:
千葉大学大学院園芸学研究院の菊池真司准教授、同大園芸学研究科博士前期課程の原一矢氏、株式会社ツムラの津坂宜宏研究員、総合研究大学院大学 統合進化科学研究センターの田辺秀之准教授、かずさDNA研究所先端研究開発部の磯部祥子博士、白澤健太博士らの共同研究チームは、漢方の原料生薬である蒼朮(ソウジュツ)の基原植物ホソバオケラ(図1)の品種改良に使われる系統が、生存には必須ではないB染色体(注1)を保有することを発見しました。さらに、ホソバオケラのB染色体は、オスとメスの両方から優先的に後代に伝達されることが明らかになりました。生存に必須ではないB染色体が生き残るための戦略(分子機構)が存在していると考えられます。
ホソバオケラのB染色体が持つ後代への優先的な伝達の仕組みの解明は、生物進化における染色体の数や形(核型)の「ゆらぎ」の理解につながります。また、B染色体のDNA配列を解読することで、品種改良への利用や、蒼朮の安定供給にもつながることが期待されます。
本研究成果は、2024年9月12日(日本時間)に、学術誌PLOS ONEで公開されました。
■研究の背景:
近年、国内の漢方製剤の市場拡大により、原料となる生薬の需要も拡大しています(図2)。しかし薬用植物は中国からの輸入に頼っており、さらに中国国内でも需要が高まっていることから、原料価格の高騰が続いています。さらに気候変動や栽培地の荒廃も加わり、生薬の供給の安定化が課題となっています。そのため国内栽培に適応した薬効成分含量が高い新品種の開発が期待されていますが、薬用植物の多くは生育が極めて遅く、育種に大きな時間を要します。そこで、ゲノム情報の解読と、ゲノム情報を利用した育種が必要となっております。

図2 漢方製剤の国内市場規模の拡大
「蒼朮」は健胃、整腸、利尿などの作用があり、国内では6番目に多く使用されている重要な生薬の一つです。その主な原料となるホソバオケラは細胞あたり24本(2n=24)の染色体を持つと考えられており、品種改良に活用されるゲノム情報やDNAマーカーの開発(注2)などは、これまで2n=24の染色体数を想定して研究が行なわれてきました。しかし、生物進化において染色体の数や形(核型)は一定ではなく、同じ種でも染色体の数や形に変化が生じていることがあります。一部の染色体が増減する異数体(例:ヒトのダウン症)や倍数体(例:ブドウの品種‘巨峰’)、性染色体(例:XX、XY型)はよく知られた例です。他に、B染色体という特殊な染色体があります。B染色体はその生物の生存に必須ではない染色体です。一方、B染色体の保有により、生育が良くなったり、あるいは悪くなったりと、その生物の形態や代謝を変化させる可能性もこれまで報告されています。
■研究の成果:
研究チームは、株式会社ツムラが保有する、様々な特徴をもつホソバオケラ54系統の染色体の数を調査しました。その結果、ホソバオケラという種の中で、2n=24、25、26の3つの核型を初めて明らかにしました(図3)。DAPIという試薬を使い蛍光顕微鏡で観察すると、2n=25や26の核型をもつホソバオケラでは、他の染色体とは異なった明るい蛍光を示す染色体が観察されました。3つの核型はこの奇異な染色体に起因しておりました。
図3 ホソバオケラの3つの核型。a-c 2n=24、25、26。それぞれ細胞あたり24、25、26本の染色体を持つ。白矢印はDAPI試薬による染色で明るく蛍光発光する染色体を示している。スケールバーは10μm
ホソバオケラは雌雄異株の植物で、雌性株(♀)と両性株(♂♀)の個体が存在します。しかし、雌性株(♀)と両性株(♂♀)の両方でこの染色体は観察されるため、性決定に直接関わる性染色体ではありませんでした。通常個体と比べても、この染色体を1~2本保有する個体(2n=25や2n=26の核型を持つ個体)は健全で、生薬成分の種類や量に顕著な影響がないことから、この染色体を、ホソバオケラを含むオケラ属で初めてとなる新規のB染色体と結論づけました。
次にB染色体のDNA配列の決定に向け、総合研究大学院大学が保有するマイクロマニピュレーター(注3)ならびにクロモソームダイセクション技術(注4)を使って、スライドガラスに張り付いた約0.005ミリメートルのB染色体を顕微鏡下で1つ1つ単離しました(図4)。さらに、解析可能なDNAの量を確保するために、かずさDNA研究所と共同で約3.7pg(ピコグラムは1兆分の1グラム)のB染色体DNAそれぞれを大量に増幅することに成功しました。この2つの実験で、増幅したB染色体のDNAを染色体上に結合させるFISH解析(注5)が可能になり、蛍光顕微鏡での観察により、B染色体に特異的な染色体マーカーの開発に成功しました。これはB染色体のDNAの単離に成功したことを証明する結果です。FISH解析により、ホソバオケラのどのB染色体も似たDNA配列を共有していることが分かりました。過去に一度起きた誕生の後、ホソバオケラB染色体は集団内で維持、拡散されたと考えられます。

図4 ホソバオケラB染色体のクロモソームダイセクションとFISH解析。a-d濃く染まったB染色体の1つ(黒矢印)に極細のガラス針(緑矢印)で狙いをつけて削り、削られた染色体の塊(赤矢印)を回収した。e-g 2n=26の系統の染色体に、回収し標識したB染色体のDNAは2本のB染色体(B1とB2)に特異的に結合した。スケールバーは10μm。
最後に、ホソバオケラのB染色体が親から子へどのように伝わるかを調べました。通常の遺伝の法則に従えば、1本のB染色体を持つ親から50%の子にB染色体が伝達されます。大規模な交配実験の結果、メス親からは~92.6%の子の個体にB染色体が伝達されました。メスの生殖組織の中で、B染色体が子に優先的に伝達される仕組みがあることを強く示唆する結果です。
また、オスの生殖組織で起こる減数分裂や生産された花粉を観察したところ、B染色体を含む花粉の割合は 期待値の50%から19~20%まで低下しておりました。ところが交配実験の結果では、興味深いことに、この親から41~47%の子の個体にB染色体が伝達されておりました。このことは、花粉にとってホソバオケラB染色体の保有は、花粉間で起こる受精競争などに打ち勝つ武器になる可能性を示しています(図5)。オスとメスの両方の性からB染色体が優先的に伝達される仕組みは、これまでのB染色体の遺伝とは異なった、とてもユニークな生き残り戦略でした。

図5 オス(花粉)から次代へのB染色体の優先的な伝達。B染色体の保有に有利性がない場合、19-20%の子がB染色体を保有すると考えられるが、41-47%の子に伝達した。
■今後の展望
現在、利用が可能なホソバオケラのゲノム情報にはB染色体の情報が含まれていないため、今後は栽培や薬用成分の種類や含量におけるB染色体の影響を調査する必要があります。単離・増幅したB染色体のDNAと次世代シークエンサー(注6)を利用して、B染色体が持つDNA配列が明らかになります。そこからPCR検査でB染色体の保有を判別するDNAマーカーを開発したり、B染色体が持つ遺伝子を調べたりすることで、ホソバオケラの品種改良に役立つかを明らかにすることができます。
同種内でも核型の変化(ゆらぎ)がよく見つかります。核型進化において、B染色体は大変興味深い研究対象であり、生存に必須ではないB染色体が進化プロセスの中で獲得した生き残り戦略の解明や産業活用にむけた研究が今後活発になることを期待しています。
■用語解説
注1)B染色体:本来もつA染色体に対し、変異が進み、過剰に存在する染色体のこと。
注2)DNAマーカー:系統などの間のDNA配列の違いを見分ける目印(マーカー)。
注3)マイクロマニピュレーター:1mmに満たない微小な対象物に対する顕微鏡操作を可能にする装置。
注4)クロモソームダイセクション:特定の染色体を物理的に削り取って回収する染色体工学的手法のこと。
注5)FISH解析:標的DNA配列を標識し、染色体上でそのDNA配列の局在を蛍光観察する方法。
注6)次世代シークエンサー: 従来のサンガーシーケンスに比べ高速で大量のDNA配列を解読できる装置。
■論文情報
タイトル:B chromosome and its non-Mendelian inheritance in Atractylodes lancea
著者:Hara K, Kikuchi S, Inoue M, Tsusaka T, Sakurai M, Tanabe H, Shirasawa K, Isobe S
雑誌名:PLOS ONE
DOI:10.1371/journal.pone.0308881
企業プレスリリース詳細へ
PR TIMESトップへ

データ提供 PR TIMES
本記事の内容に関するお問い合わせ、または掲載についてのお問い合わせは株式会社 PR TIMES (release_fujitv@prtimes.co.jp)までご連絡ください。また、製品・サービスなどに関するお問い合わせに関しましては、それぞれの発表企業・団体にご連絡ください。



